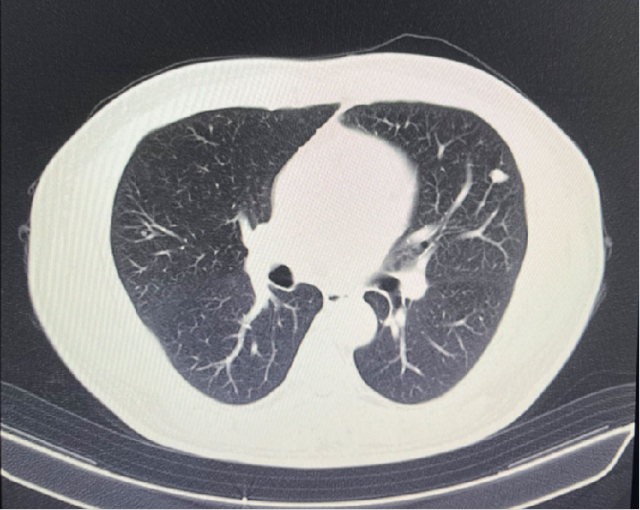
图片8.png

患者:贾XX,男,39 岁。
主诉:左肾癌术后 2 年余。
现病史:患者于 2 年余因血尿至郑大一附院就诊,经完善检查诊断为「左肾肿瘤」,后于 2020 年 8 月 28 日行全麻下行「腹腔镜左肾根治性切除术」,术后病理示:(左肾切除标本)肾细胞癌,结合形态及免疫组化,较符合乳头状肾细胞癌,II 型。术后口服「培唑帕尼」治疗,10 个月后因腹泻、高血压,自行停药。复查 CT 示:左肺上极及右肺中叶小结节,左肺上极小结节较前密度稍高。今为进一步治疗来我院就诊,门诊以「左肾癌术后腹膜后淋巴结转移」为诊断收入院。
既往史、个人史、家族史:均余无特殊。



诊断
考虑为:左肾癌术后肺转移(T1N1M1)
T1:术前肿瘤最大径 3cm
N1:肾门淋巴结阳性
M1:左肺结节
病人暂不考虑手术切除肺部病灶
双肺多发结节
可疑结节直径较小
给予阿昔替尼联合特瑞普利单抗治疗
影像学检查
2023-05-03:


2023-08-01:

2023-11-08:


2024-02-28:


2024-05-17:


治疗方案变更
靶免联合治疗期间
出现蛋白尿(2023.08)
手足综合征及高血压
更换为伏罗尼布继续治疗(2024.05)
治疗过程

问题探讨
1. 靶免联合治疗期间出现蛋白尿(2023.08)
是否需减量或停药?
长期蛋白尿是否影响肾功能?是否是较为严重的问题?
2. 病情稳定近两年(2022.08-2024.05)
能否停用 TKI,单用免疫维持?
复查 PET-CT 后,肺部单发病灶放疗?
病例 1
55 岁,男性,2021 年因体检发现左肾占位入院。
CT:1. 左肾下极占位性病变:肾 CA? 2. 双肺多发囊肿;3. 双肾小结石;4. 肝 S4 段强化灶;5. 肝多发囊肿。
2021.10.14 行腹腔镜下左肾部分切除术。
术后病理:乳头状肾细胞癌,II 型,ISUP 分级 G3 级。脉管内未见瘤栓,未见神经周侵犯。

2023.12 开始靶免联合治疗

2025.1开始伏罗尼布+依维莫司联合治疗
2025.1 开始更换伏罗尼布+依维莫司双靶治疗,病情控制稳定。
目前暂未出现明显 AE,疗效正在随访中。
非透明细胞类型肿瘤后线治疗。

病例 2
66 岁,男性,2024 年因血尿 2 天,体检发现右肾占位入院。
CT:1. 右肾癌伴右肾静脉受累,侧支循环形成;2. 右肾上腺结合部结节灶,转移可能;3. 右输尿管上段管壁局部增厚:侵犯?4. 左肾囊肿。
PETCT:1. 右肾中-下份混合密度软组织肿块,糖代谢轻度升高,SUVmax6.4, 右肾内糖代谢稍增高灶,SUVmax3.8,右肾癌合并肾静脉瘤栓形成;2. 右肾上腺结合部低密度灶,糖代谢轻度增高,转移瘤,SUVmax3.1。

围手术期治疗
2021.10.14 行腹腔镜下右肾根治性切除术+右肾上腺肿瘤切除术。
术后病理:透明细胞性肾细胞癌,ISUP 分级 G3 级;肿瘤性坏死:20%;肾静脉及腔静脉壁浸润;肾上腺皮脂腺瘤。pT3NxMx

肾癌免疫治疗中国专家共识
KEYNOTE-564 研究 [1] 提示,帕博利珠单抗用于 ccRCC 辅助治疗可显著降低 38% 的死亡风险;一项纳入 4 项研究的 Meta 分析 [2] 显示,接受免疫辅助治疗的程序性死亡配体 1(PD-L1) 阳性和肉瘤样分化人群中,DFS 获益显著。
共识推荐:pT2 分期伴 WHO/ISUP 核分级 4 级或肉瘤样分化的 ccRCC 患者,pT3 及以上分期的 ccRCC 患者及区域淋巴结转移或无疾病证据的远处转移患者接受帕博利珠单抗辅助治疗,其中优先推荐 PD-L1 阳性和肉瘤样分化患者。鉴于帕博利珠单抗尚未在国内获批肾癌治疗适应症,需结合临床环境,与患者及家属充分沟通后,谨慎尝试使用国内可及的免疫检查点抑制剂(如特瑞普利单抗等)进行辅助治疗。
1.Choueiri TK,Tomczak P,Park SH,et al. Overall survival with adjuvant pembrolizumab in renal-cell carcinoma[J]. N Engl J Med,2024,390(15):1359-1371.
2.Riveros C,Huang E,Ranganathan S,et al. Adjuvant immunotherapy in renal cell carcinoma:a systematic review and meta-analysis[J]. BJU Int,2023,131(5):553-561.
2024.10开始特瑞普利单抗免疫治疗
CT(2024.7.31):「右肾根治性切除术 + 肾上腺肿瘤切除术后」改变,未见术区复发,建议追踪。
CT(2024.10.17):1.「右肾根治性切除术 + 肾上腺肿瘤切除术后」改变,未见术区复发,建议追踪。2. 双肺多发微小结节,建议追踪复查。

2025.1 开始伏罗尼布单靶治疗
特瑞普利单抗治疗过程中出现 AE,后更换伏罗尼布单靶治疗,治疗效果仍在随访中。
CT(2025.2.20):1.「右肾根治性切除术 + 肾上腺肿瘤切除术后」改变,未见术区复发,建议追踪。2. 双肺多发微小结节基本同前。
局部晚期透明细胞类型肿瘤辅助治疗。

病例 3
58 岁,男性,2022 年因发现左肾透明细胞癌半年入院。
既往:右肾结石多次手术,右肾无功能。
入院肌酐:110.5μmol/L
CT(2022.1):1. 左肾肿块,肾癌并出血可能;2. 左输尿管上段结石并周围炎症,左肾结石并积水;3. 右肾萎缩;4. 肝囊肿。



免疫时代围手术期治疗理论基础
新辅助免疫治疗
机体行免疫治疗后产生的免疫激活效应可以消灭肿瘤微转移 1
或消除手术过程中释放到循环中的活肿瘤细胞 4
病理反应提供了治疗反应的早期指标,并可以指导未来的治疗决策 3
提高治疗开始率和依从性 2
1.Lewis. Front Oncol. 2018;8:5. 2. Felip. JCO. 2010;28:3138. 3. Hellmann. Lancet Oncol. 2014;15:e42.
2. McElnay. J Thorac Dis. 2014;6 Suppl 2:S224. 6. Yuan. Signal Transduct Target Ther. 2019;4:61.
3. Owen. J Thorac Dis. 2018;10(suppl 3):S404.
4. Xie. Am J Cancer Res.2021;11:2521.
2022.1 靶免联合新辅助治疗
新辅助治疗前

新辅助治疗后

治疗后复查 CT(2022.7):左肾透明细胞 CA 治疗后改变,肿块较前缩小,强化程度减低,左侧副肾动脉可见;余况同前。
围手术期治疗
2022.7.11 行腹腔镜下左肾部分切除术。
术后病理:透明细胞肾细胞癌,ISUP 分级 G2 级,未见脉管内癌栓及神经周侵犯。

术后复查:肌酐 207.3umol/l

2024.4 开始使用培唑帕尼靶向单药治疗
CT( 2024.4.26 ):1. 左肾 NSS 术后改变,左肾新见多发结节状等密度灶,考虑复发;2. 右输尿管上段结石消失,右肾积水缓解,右肾萎缩;3. 余况同前。
培唑帕尼用药 5 月,因 AE 导致停药。


2024.8 开始更换伏罗尼布靶向单药治疗。
CT( 2024.12.5 ):1. 左肾 NSS 术后改变,左肾多发结节状等密度灶较前稍缩小;2. 右肾功能受损,同前相仿;3. 余况同前。
更换伏罗尼布单药 3 月,肿瘤评估 PR。


病例 4
73 岁,男性,右肾透明细胞癌根治术后 10 年,发现左肾上腺 3 月入院。
既往:2022.5 肺转移瘤切除史(透明细胞癌)。
CT(2022.7):1. 右肺转移瘤切除术后改变;2. 左肾上腺结节,转移?3. 左肾多发结节,转移瘤?4. 腹膜后淋巴结肿大,转移可能;5. 左肾多发小囊肿。

2022.10 开始予以靶免联合治疗
PETCT(2022.10):1. 左侧肾上腺结节灶,糖代谢增高,转移瘤可能性大;2. 左肾多发结节状突起,糖代谢增高,考虑转移瘤,需结合增强 CT 综合判断;3. 右下肺切除术后,术区未见复发;4. 右侧胸壁局部增厚、糖代谢增高,术后改变?建议追踪。

靶免联合治疗 1 年后复查
CT(2023.7.17):1. 左肾上腺结节、左肾结节及肿块较前明显增大:转移?左肾 CA 并左肾内、肾上腺转移?2. 腹膜后淋巴结较前增大,转移可能;3. 余况基本同前。

2023.7 开始予以伏罗尼布单靶治疗
CT(2023.12.6):1. 左肾上腺结节较前稍缩小、左肾结节及肿块较前稍缩小;2. 腹膜后淋巴结转移灶同前;3. 余况基本同前。

肝、肾功能变化情况

伏罗尼布治疗 2 年后病变进展
CT(2025.4.7):1. 左肾上腺肿块较前明显增大;2. 左肾结节及肿块部分较前增大;3. 腹膜后淋巴结同前;4. 右侧胸膜结节状增厚较前增大,建议追踪;5. 余双肺情况基本同前。
孤立肾肿瘤多发转移后线治疗。

2025.4.28 姑息性肾脏切除 + 肾脏替代治疗
孤立肾肿瘤多发转移后线治疗。

小结

病例 5
63 岁,男性,左肾透明细胞癌根治术后 12 年,发现双肺多发转移瘤 1 月。
既往:无特殊。
术后病理:左肾透明细胞癌 II 级,侵及肾被膜及输尿管,肾周脂肪、左肾上腺未见癌。CT(2024.4):1. 左肾癌根治术后改变,未见术区复发;2. 左肺下叶基底段肿块、左叶间裂结节灶;3. 右肺上叶后段多发结节灶;4. 左第 3 肋、11 肋,右第 6 肋多发骨质破坏;5. 纵膈淋巴结肿大;6. 肝内多发低密度灶;7. 胰腺体尾部片状强化减低灶。

2024.4 开始靶免联合治疗
CT(2024.9):1. 左肾癌根治术后改变,术区未见复发;2. 右肺上叶后段斜裂旁新见结节灶,考虑进展;3. 后纵隔淋巴结较前增大,考虑进展;4. 余双肺结节大致同前;5. 肝内多发低密度灶同前;6. 胰腺体尾部片状强化减低灶同前,主胰管扩张较前明显,建议追踪。

2024.9 更换伏罗尼布+依维莫司治疗
CT(2025.3):1. 左肾癌根治术后改变,术区未见复发;2. 右肺上叶后段斜裂旁结节灶较前缩小;3. 后纵隔淋巴结较前稍缩小;4. 余双肺结节大致同前;5. 肋骨多发骨质破坏同前;6. 胰腺体尾部片状强化减低灶同前,主胰管扩张较前减轻。

不同部位肿瘤变化情况
晚期肾癌后线治疗。

小结

病例 6
张某某,55 岁女性,
主诉:活动后气促 1 月余,检查发现右肾肿瘤并腔静脉 II 级瘤栓。
体查、既往史、家族史(-)
外院行穿刺活检:(右肾结节)穿刺活检,可见异型细胞,巢团状分布,局部肾实质见片状淋巴细胞浸润,可见肉芽肿性炎,免疫组化:2403798 -A01#:CK(pan)(+)、EMA(-)、Pax -8(+)、CA IX(+)、CK7(-)、CD10(-)、Vimentin(+)、p504s (+)、SDHB(+)、FH (+)、Melanoma(-)、CD117(-)、TFE - 3(个别弱 +)、Ki67(+,5-10%)。
结合免疫组化考虑肾细胞癌,倾向乳头状肾细胞癌,建议结合切除肿块病检进一步诊断,其中肉芽肿性炎的具体病原体类型请结合分子病理报告。
2024.1检查报告
CT 检查报告
1.左肺动脉主干及分支、右下肺动脉分支多发肺栓塞;
2.下腔静脉、右肾静脉及其属支、左肾静脉及左侧髂总静脉多发血检形成,请结合临床。
3.双肺散在炎症,双侧胸膜增厚;
4.右肾大片状低强化灶,请结合临床。
日期:2024.1.10

CT 检查报告
1.左肺动脉主干及分支多发肺栓塞较前范围扩大,右上肺后段动脉、右中肺外侧段动脉内肺栓塞,右下肺动脉分支内肺栓塞较前稍吸收减少;
2.右肾静脉及其属支充盈缺损较前相仿,左肾静脉充盈缺损较前范围缩小,下腔静脉、左侧髂总静脉内多发充盈缺损较前范围扩大;
3.双肺散在炎症较前減少,双侧胸膜增厚;
4.左肺上叶尖后段磨玻璃结节,性质待定 建议复查;
5.右肾大片状低强化灶,请结合临床。
日期:2024.1.22

伏罗尼布+依维莫司新辅助靶向治疗
CT 检查报告
1.左肺动脉主干及分支、右下肺动脉分支多发肺栓塞;
2.下腔静脉、右肾静脉及其属支、左肾静脉及左侧髂总静脉多发血检形成,请结合临床。
3.双肺散在炎症,双侧胸膜增厚;
4.右肾大片状低强化灶,请结合临床。
日期:2024.1.10
CT平扫+增强
检查诊断:
1.下腔静脉管腔较前缩小、充盈缺损较前略减少;
2.右肾静脉栓子同前;左肾静脉充盈缺损未见显示;双侧骼静脉充盈欠佳;
3.右肾上极病变同前:恶性肿瘤可能;右肾盂管壁增厚强化:受累?
4.盆腔少量积液;
5.右肝动脉起自肠系膜上动脉;左下肺动脉栓子;
日期:2024.3.3
CT 报告
1.下腔静脉管腔较前缩小、充盈缺损较前减少;
2.右肾静脉栓子较前减少;右侧髂总静脉内少许栓子;
3.右肾上极病变较前缩小,右肾孟管壁受累较前减轻;
4.盆腔少量积液较前减少;
5.左下肺动脉栓子形成,范围较2024-01-22日稍缩小;
6.左肺上叶结节较前稍增大,性质待定;
7.双肺下叶少许条索较前减少。
日期:2024.3.21
直接减影血管成像
1. 下腔静脉管腔较前缩小、充盈缺损较前相仿;
2. 右肾静脉、右侧髂总静脉栓子较前减少;
3. 右肾上极病变较前缩小,右肾盂管壁受累较前相仿;
4.盆腔积液现已吸收;
5.左下肺动脉栓子较前相仿;
6. 左肺上叶结节较前相仿;
7.双肺下叶少许条索较前减少
日期:2024.4.30
CT 肾脏平扫增强三维+肾血管成像 CTA+CTV,CT 肺部平扫+肺动脉成像 CTA
1.右肾上极稍低密度肿块灶及肾盂、输尿管上段壁明显增厚:考虑恶性病变,伴右肾静脉-下腔静脉-左肾静脉起始部癌栓形成可能性大,请结合临床。
2.右中肺外侧段肺动脉、左肺动脉干、左上下肺动脉多发栓塞。
3.左肺上叶尖后段混杂磨玻璃结节,LU-RADS 4B类,建议多学科会诊。
4.支气管炎。双肺下叶胸膜下少许炎症。
5.甲状腺双侧叶强化减低灶,建议结合超声检查。
6.左侧肾上腺结合部、内侧肢局限性增粗,意义待定。
日期:2024.5.29
双靶治疗(2个月)

双靶治疗(4个月)

2024.6.12 行根治性肾切除+腔静脉瘤栓取出术
术后大体标本

小结
